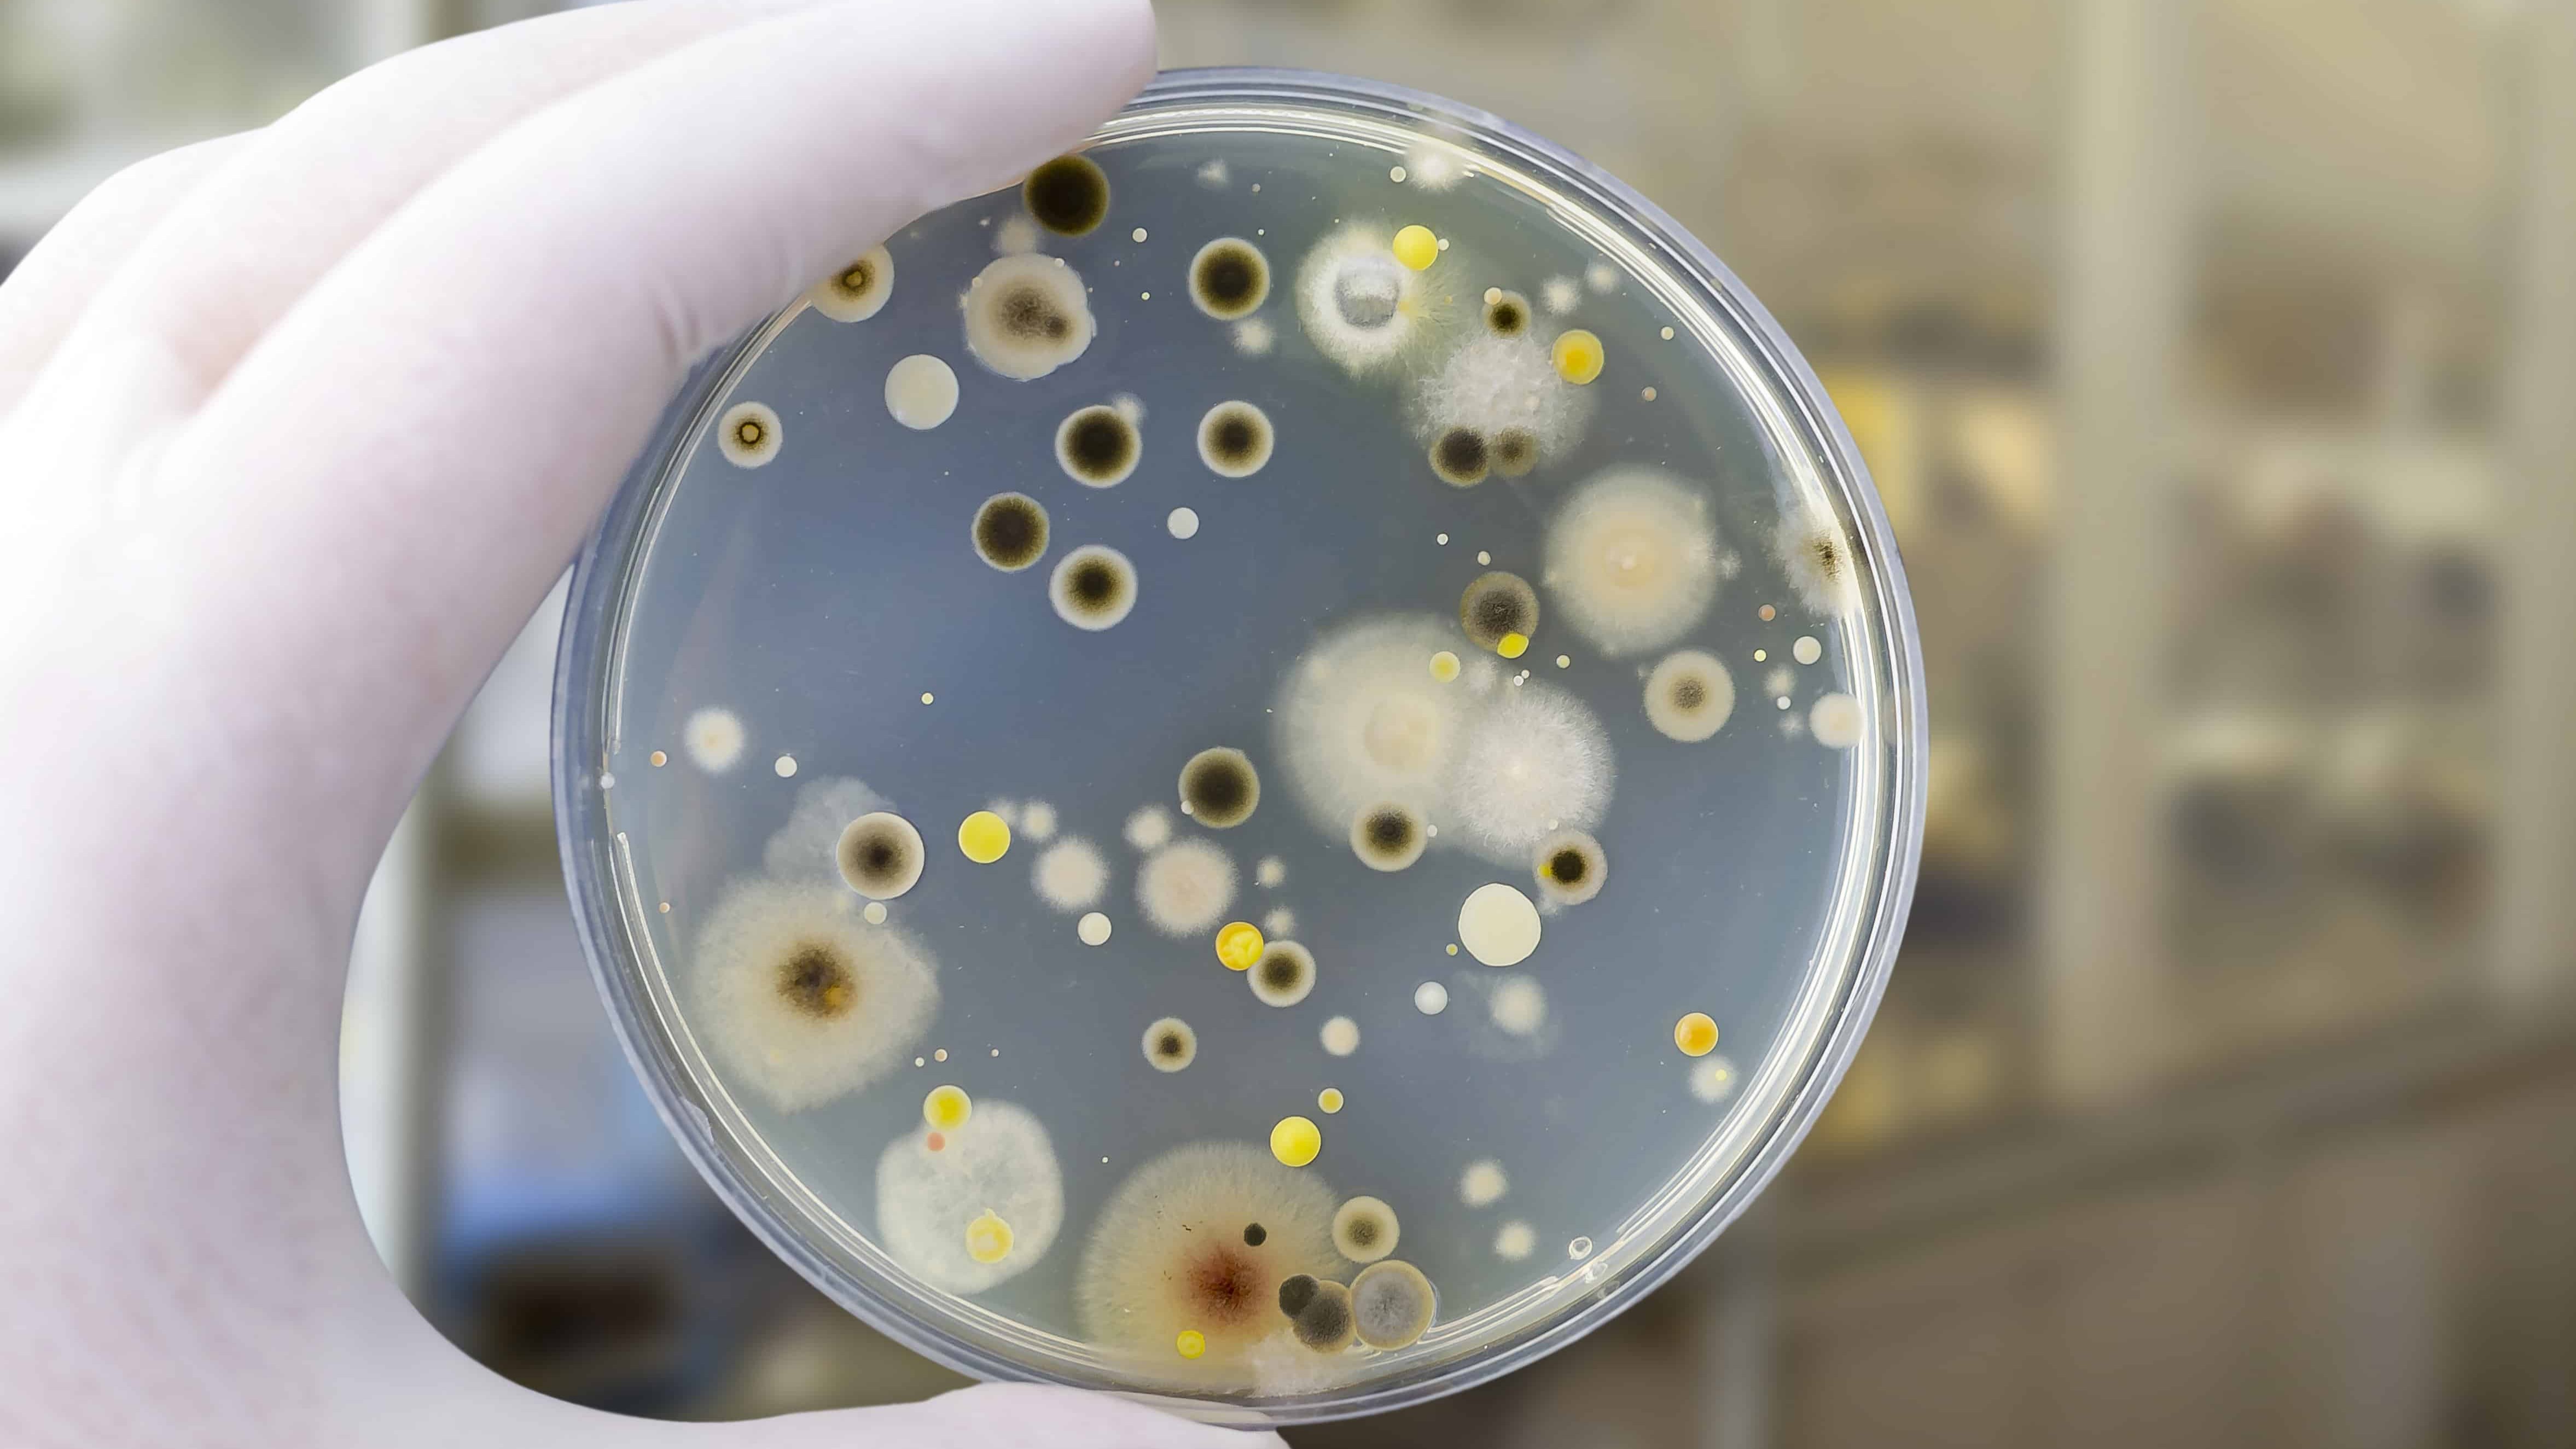
Mold Testing in Greystone

We discuss your concerns and customize the testing plan
Certified technician collects air and surface samples
Samples sent to accredited laboratory for analysis
Receive comprehensive results with expert recommendations
Identify and quantify mold spores in your indoor air

Detect common allergens affecting air quality

Evaluate your ventilation system for contamination

Measure volatile organic compounds in your air
Poor indoor air quality can cause or contribute to the development of infections, lung cancer, and chronic lung diseases like asthma. It can also cause headaches, dry eyes, nasal congestion, nausea and fatigue.
Coughing, wheezing, shortness of breath
Sneezing, runny nose, itchy eyes
Unexplained tiredness or dizziness
Frequent or persistent headaches
Schedule your air quality inspection today and get certified results within 72 hours
© 2025-2026. 5 Star Services LLC. Rights Reserved.
Website Development |
Hosting | SEO | Digital Marketing
